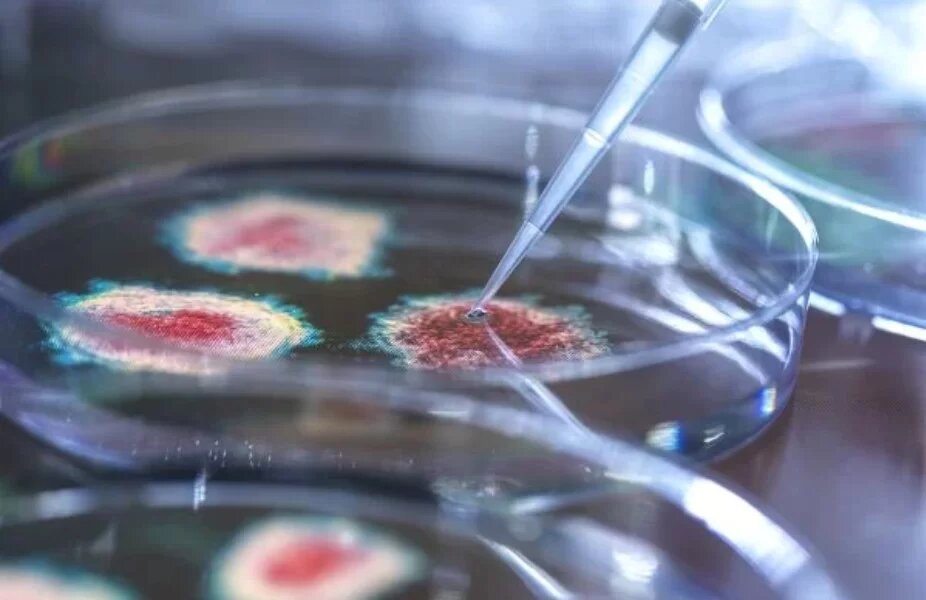
Descubren un organismo que se alimenta de virus

Si nombras cualquier materia orgánica que se te venga a la mente, es probable que esta haya evolucionado para comerla. Siempre habrá una criatura que consuma planta, carne, algas, insectos o bacterias, sin embargo, nunca se había descubierto alguna que comiera virus… hasta ahora.
Organismo se alimenta de virus

Debido a que están en todas partes, es inevitable que los organismos lo consuman accidentalmente, pero el investigador John DeLong, de la Universidad de Nebraska-Lincoln, quería saber si algún microbio comía virus activamente y si esa dieta podría favorecer el crecimiento fisiológico de los individuos poblacionales de una comunidad.comer,estu
«Están compuestos de cosas realmente buenas: ácidos nucleicos, mucho nitrógeno y fósforo. Todo el mundo debería querer comérselos. Muchas cosas comerán cualquier cosa que puedan conseguir. Seguramente alguien habría aprendido a comer estas materias primas tan buenas”.
Para probar su hipótesis, DeLong y su equipo recolectaron muestras de agua de estanque, asilaron distintos microbios y, después, agregaron grandes cantidades de clorovirus, un habitante de agua dulce que infecta las algas verdes. Los días siguientes, el equipo rastreó el tamaño de la población de los virus y de los otros microbios para ver si estos últimos realmente se comían a los primeros.
Un nuevo hallazgo
Los resultados fueron positivos, un microbio en particular parecía estar comiéndolos: un ciliado conocido como Halteria. En muestras de agua sin otra fuente de alimento para los ciliados, las poblaciones como Halteria crecieron unas 15 veces en dos días, mientras que los niveles de clorovirus se redujeron 100 veces. En el escenario opuesto, la Halteria no creció.
En pruebas de seguimiento, el equipo marcó el ADN del clorovirus con un tinte fluorescente y descubrió que las células de Halteria rápidamente empezaron a brillar. Esto ayudó aconfirmar que Halteria efectivamente estaba comenzando el virus.
Dichos experimentos demuestran que el término recién acuñado “vivovory” ahora puede ocupar su lugar entre herbivoría, carnivoría entre los demás, con Halteria corona como la primera viróvoro conocida. Pero, claramente es muy proco probable que sea el único que existe, y los expertos planean seguir investigando este fenómeno, incluyendo los efectos en las redes alimentarias y los sistemas más grandes, como el ciclo del carbono.
La investigación fue publicada en la revista Proceedings of the National Academy of Sciences.
Related
Descubre más desde Cerebro Digital
Suscríbete y recibe las últimas entradas en tu correo electrónico.
